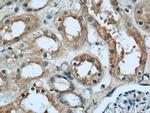
GNAI3 Antibody in Immunohistochemistry (Paraffin) (IHC (P))

Search
Proteintech
GNAI3 Polyclonal Antibody
{{$productOrderCtrl.translations['antibody.pdp.commerceCard.promotion.promotions']}}
{{$productOrderCtrl.translations['antibody.pdp.commerceCard.promotion.viewpromo']}}
{{$productOrderCtrl.translations['antibody.pdp.commerceCard.promotion.promocode']}}: {{promo.promoCode}} {{promo.promoTitle}} {{promo.promoDescription}}. {{$productOrderCtrl.translations['antibody.pdp.commerceCard.promotion.learnmore']}}
产品信息
11641-1-AP
种属反应
宿主/亚型
分类
类型
抗原
偶联物
形式
浓度
规格
纯化类型
保存液
内含物
保存条件
运输条件
产品详细信息
Immunogen sequence: MGCTLSAED KAAVERSKMI DRNLREDGEK AAKEVKLLLL GAGESGKSTI VKQMKIIHED GYSEDECKQY KVVVYSNTIQ SIIAIIRAMG RLKIDFGEAA RADDARQLFV LAGSAEEGVM TPELAGVIKR LWRDGGVQAC FSRSREYQLN DSASYYLNDL DRISQSNYIP TQQDVLRTRV KTTGIVETHF TFKDLYFKMF DVGGQRSERK KWIHCFEGVT AIIFCVALSD YDLVLAEDEE MNRMHESMKL FDSICNNKWF TETSIILFLN KKDLFEEKIK RSPLTICYPE YTGSNTYEEA AAYIQCQFED LNRRKDTKEI YTHFTCATDT KNVQFVFDAV TDVIIKNNLK ECGLY (1-354 aa encoded by BC025285)
靶标信息
Heterotrimeric G proteins function to relay information from cell surface receptors to intracellular effectors. Each of a very broad range of receptors specifically detects an extracellular stimulus (a photon, pheromone, odorant, hormone or neurotransmitter) while the effectors (i. e. adenyl cyclase), which act to generate one or more intracellular messengers, are less numerous. In mammals, G protein alpha, beta and gamma polypeptides are encoded by at least 16, 4 and 7 genes, respectively. Most interest in G proteins has been focused on their alpha subunits, since these proteins bind and hydrolyze GTP and most obviously regulate the activity of the best studied effectors. Four distinct classes of Galpha subunits have been identified; these include Gs, Gi, Gq and Galpha 12/13. The Gi class comprises all the known alpha subunits that are susceptible to pertussis toxin modifications, including Galpha i-1, Galpha i-2, Galpha i-3, Galpha o, Galpha t1, Galpha t2, Galpha z and Galpha gust. Of these, the three Galpha i subtypes function to open atrial potassium channels.
仅用于科研。不用于诊断过程。未经明确授权不得转售。
生物信息学
蛋白别名: G protein; G protein alpha subunit; G(i) alpha-3; GTP-binding protein alpha subunit; guanine nucleotide binding protein (G protein), alpha inhibiting activity polypeptide 3; guanine nucleotide binding protein, alpha inhibiting 3; guanine nucleotide-binding protein (G) alpha subunit; guanine nucleotide-binding protein G(i) subunit alpha; Guanine nucleotide-binding protein G(i) subunit alpha-3; guanine nucleotide-binding protein G(k) subunit alpha; guanine nucleotide-binding regulatory protein alpha-inhibitory subunit; heterotrimeric guanine nucleotide-binding protein 1A; unnamed protein product
基因别名: 87U6; AI158965; ARCND1; ARCODS; AW537698; Galphai3; Gnai-3; GNAI3; HG1A
UniProt ID: (Human) P08754, (Mouse) Q9DC51
Entrez Gene ID: (Human) 2773, (Mouse) 14679